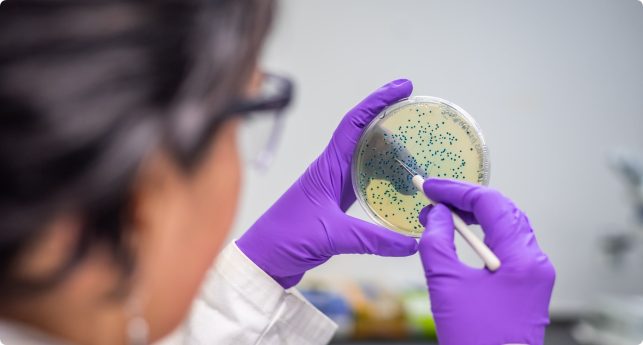

Business Development & Sales
Jobs include Territory Managers, Account Managers, Area Sales Representatives and Sales Managers. Expect new business development, cold calling, relationship management, lead generation and territory mapping.
In addition to our market leading temporary staffing service, Agenda will connect you with opportunities to work with animals on a permanent basis. Roles typically include: Animal Technicians, Laboratory Scientists and In Vivo Researchers.
Get In TouchJobs include Territory Managers, Account Managers, Area Sales Representatives and Sales Managers. Expect new business development, cold calling, relationship management, lead generation and territory mapping.
Interested in how and why substances combine and/or separate with other substances and how they interact with energy? Agenda are well placed to help further your career within key subject areas including: Analytical, Physical, Organic, Inorganic and Biochemistry.
Experience in the field of genetics can lead to careers in scientific research, as well as pharmacology, with skills like logical thinking, numeracy, ethical debate knowledge, computing and interpretation of scientific data all useful in this area.
Varied roles often requiring both In Vivo and In Vitro techniques. Duties often include: tissue collections, sample preparation, sectioning, embedding, trimming, staining and using a microtome. Histology skills often are used in other lab-based disciplines and roles and offer versatility in a variety of environments.
The complete and extensive discipline of medicine with borders that overlap many other clinical and basic sciences. A background and skills in Immunology can lead to work in numerous sectors including healthcare, pharmaceuticals and veterinary medicine. Onco-Immunology remains a ‘hot topic’ in science and a key growth area in the UK.
Get In TouchMicrobiologist facilitate developments in healthcare and the prevention/transmission of diseases, in roles that work closely with other fields including Molecular Biology, Biochemistry and Immunology. Key areas of experience for Microbiologists in the Life Science sector are often: GLP experience, expertise in aseptic techniques and culturing.
Get In TouchThe main focus lies on the understanding of cell interactions, the connections of DNA, RNA and Protein Synthesis and how these interactions are regulated. Key techniques include: cloning, PCR, electrophoresis, blotting, microarrays and ELISA.
Often known as Neural Science, this subject area covers the study of the brain and the nervous system. Research is often conducted using In Vivo and In Vitro techniques and is focussed on specialist disciplines such as neurodegenerative diseases, behavioural research, pain studies, cognitive function and neurological disorders.
The study of tackling all things cancer related. Agenda are proud to work in close partnership with key organisations and institutions focused on the development of treatment and future prevention.
The branch of pharmaceutical sciences which focuses on the study of the actions of drugs. Pharmacology is made up of two key areas; Pharmacodynamics and Pharmacokinetics. Don’t hesitate to get in touch if you’re looking for work with anti-cancer drug development and/or ADME.
Isolating, identifying, measuring toxic substances, defining and reporting harmful effects, advising on safe use, dosage and side effects all fall under the Toxicology umbrella. In a busy and rapidly developing marketplace, Agenda can connect you with work in safety assessment, reproductive studies and environmental toxicology.
Get In Touch